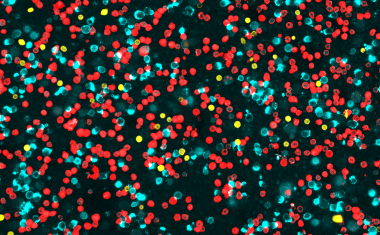
Photo

Multiples Myelom: Brechen Krebszellen aus entsteht gefährliche Vielfalt
Ein Forschungsteam hat neue Details zur Ausbreitung des unheilbaren Knochenmarkkrebses „Multiples Myelom“ im Körper entdeckt.

Ein Forschungsteam hat neue Details zur Ausbreitung des unheilbaren Knochenmarkkrebses „Multiples Myelom“ im Körper entdeckt.

Mit einer neuartigen Mikroskopie-Methode haben Wissenschaftler des CeMM und der Medizinischen Universität Wien ein Verfahren erprobt, das anhand von Blutproben von Rheumapatienten das individuell geeignetste zugelassene Medikament vorhersagen kann.

Immunzellen sind dazu in der Lage, Infektionen wie ein Spürhund zu „erschnüffeln“. Sie nutzen dazu spezielle Sensoren, die n Toll-like-Rezeptoren (TLR).
Forschende des Fraunhofer-Instituts für Toxikologie und Experimentelle Medizin ITEM haben mit der Chipzytometrie ein Verfahren etabliert, mit dem man die Immunzellen der Lunge charakterisieren kann.

Ein internationales Forschungsteam unter Basler Leitung hat eine Verbindung zwischen der Darmflora und Entzündungsherden im zentralen Nervensystem bei Multipler Sklerose entdeckt.

